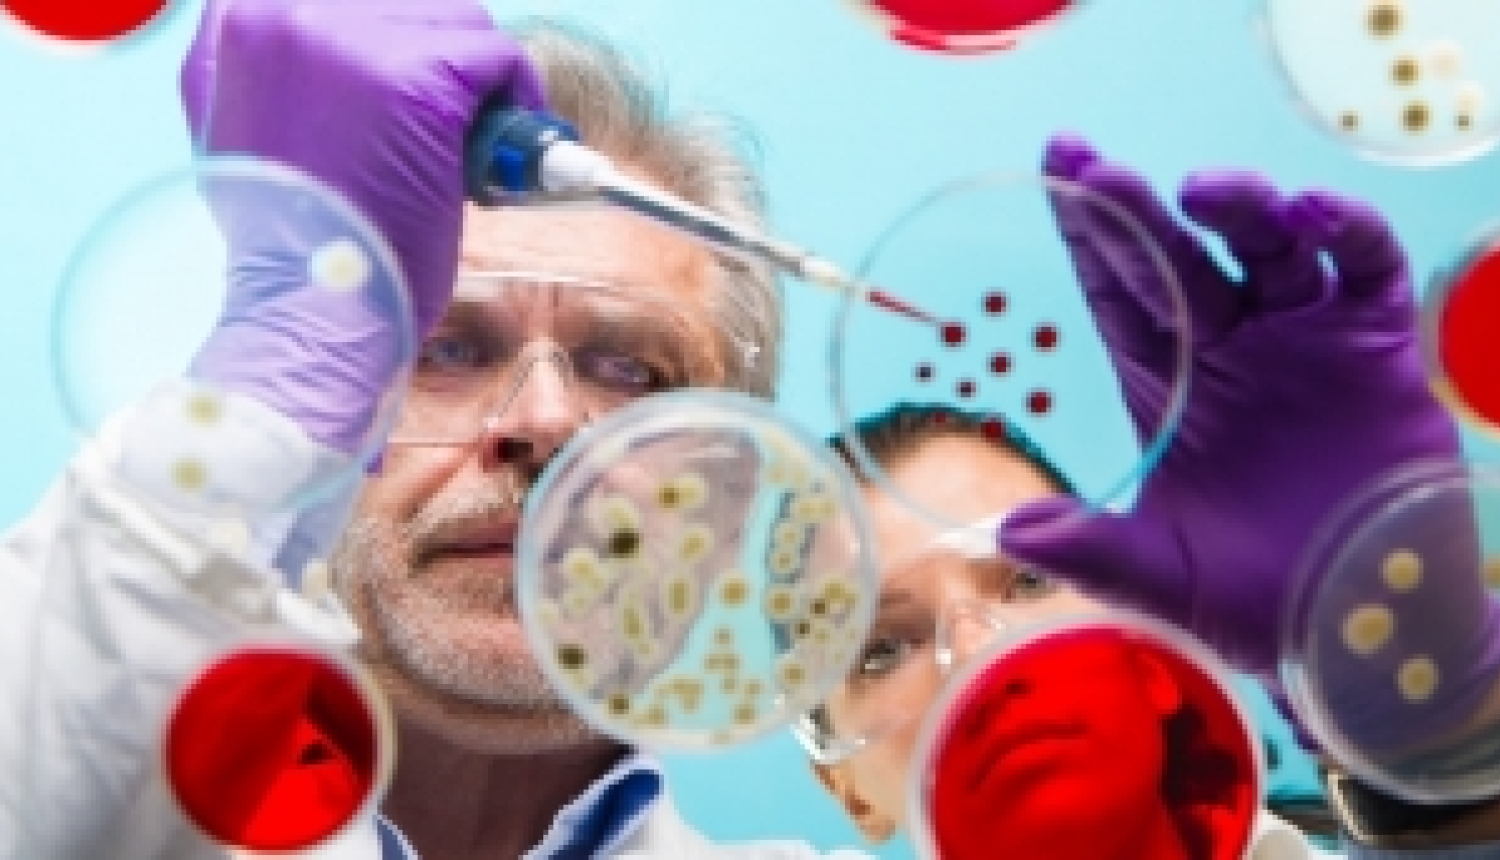
Iespēja pieteikt pētniecības projektus JPI-EC-AMR konkursā

2018. gada 14. decembrī ir izsludināts JPI-EC-AMR jauns projektu konkurss “Antimikrobiālās rezistences diagnostika un uzraudzība”, kurā projektu uzsākšana paredzēta 2019. gada nogalē.
Konkursā aicinām iesūtīt pieteikumus, kas saistīti ar jaunu diagnostikas instrumentu, tehnoloģiju un metožu izstrādi, kas ļauj noteikt antimikrobiālo rezistenci. Uzsaukuma kopējais budžets ir vairāk nekā 18 miljoni eiro.
Projektu pieteikumu iesniegšana ir paredzēta divās kārtās:
- pirmās kārtas projektu pieteikumu iesniegšanas termiņš ir 2019. gada 18. februāris 11:00 CET;
- otrās kārtas projektu iesniegšanas termiņš 2019. gada 17. jūnijs 11:00 CET.
Piesakot projektu, konsorcijā jābūt pārstāvētām vismaz trim dažādām valstīm, kas piedalās konkursā. Konsorcija dalībnieku skaits ir trīs līdz seši.
Detalizēta informācija par projektu JPI-EC-AMR mājaslapā.
Projektu konkursa uzsaukums angļu valodā: šeit.
Papildus informācija:
Uldis Berķis
Pētniecības starptautisko programmu nodaļas
Vecākais eksperts
E-pasts: uldis.berkis@viaa.gov.lv
Tālr.: +371 29472349